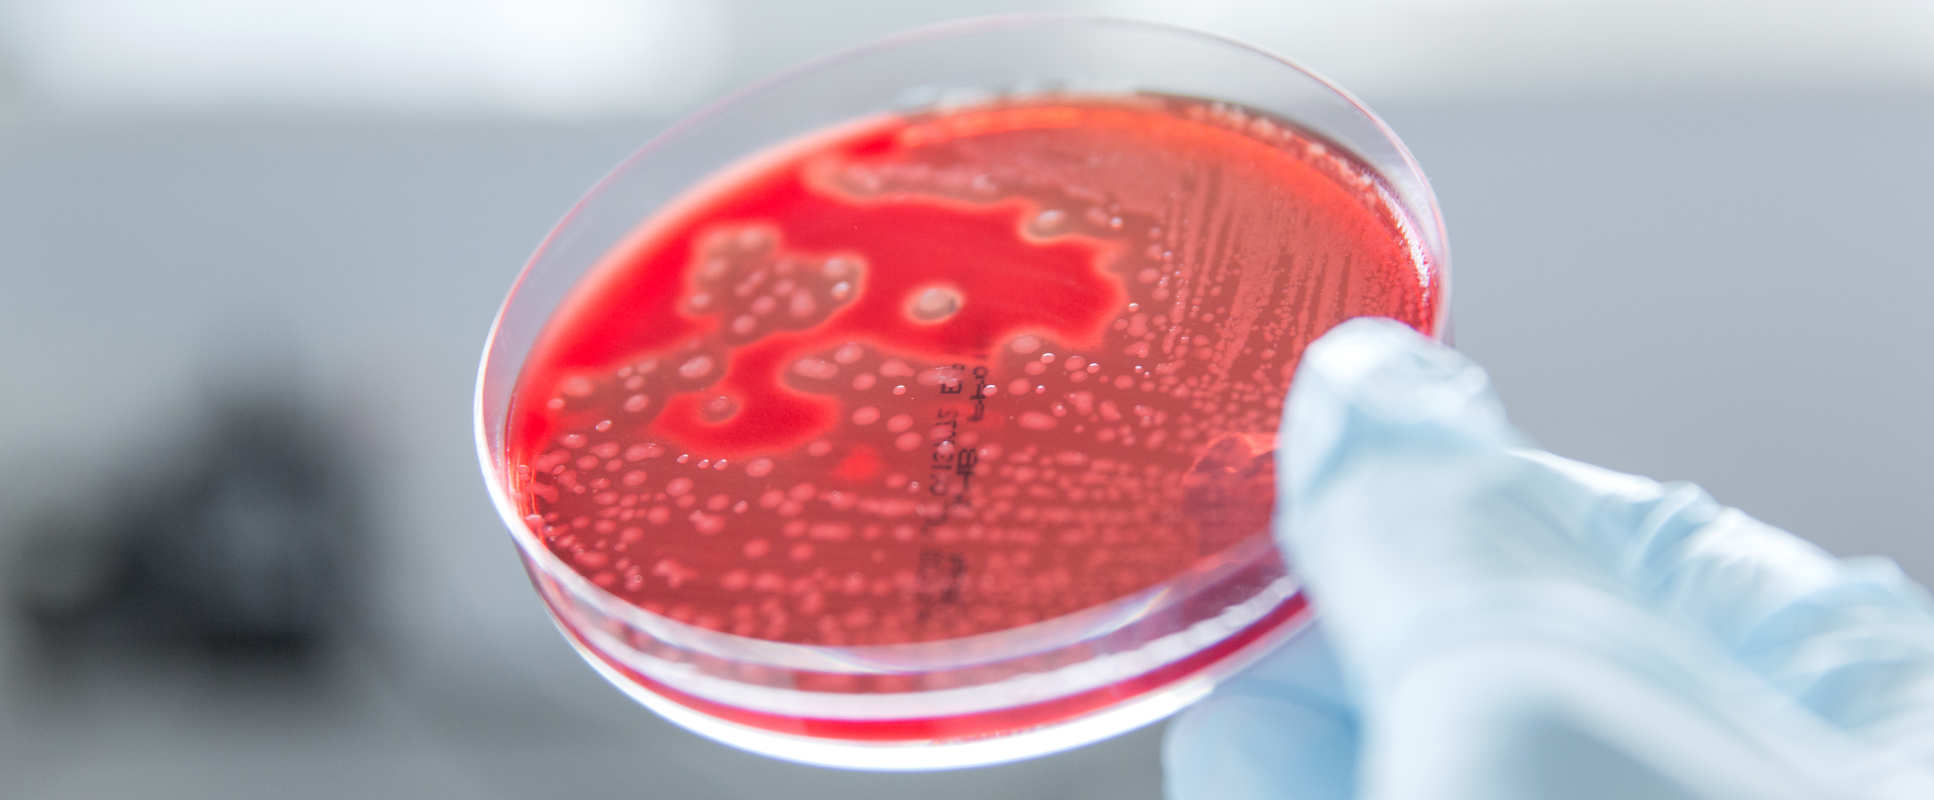

Quality assurance and control
Key contributors
- Imperial College London
- NIBSC
- GSK Vaccines Institute for Global Health (GVGH, Italy)
- Cambridge
- NHS BT-CBC
- LMIC partners
Submit a contact request
Challenge and opportunity
Often Quality -Assurance / -Control of vaccine qualification together with regulatory approval provides the greatest rate-limiting step for rapid vaccine deployment, hence streamlining these processes will be a key aspect of the program.
Through our partnership with National Institute for Biological Standards and Control (NIBSC), we will provide access to reference material and assays designed to help convergence in the QA of existing and new vaccine products and their regulatory approval.
NIBSC deals with all quality aspects of vaccines and works in collaboration with external stakeholders performing prequalification (PQ) testing on behalf of the World Health Organization (WHO) to ensure the quality of vaccines purchased by United Nations (UN) agencies for use in developing countries.
Methodology
Through this Workstream, the Hub in partnership with the NIBSC will work with partners in the UK, GSK Vaccines (GVGH), and LMIC manufacturers to identify and develop reference materials needed to control and validate assays for the quality of existing vaccines and develop new assays as required.
The NIBSC team have multiple links with the UK, and other international regulatory agencies and who support LMIC manufacturers in navigating the best route to get WHO prequalification in such settings where regulatory and ethical review is in its infancy.
In addition, we will develop/validate simple point-of-care tests as a final QA check before the vaccine is administered in the clinic; and apply developing scientific approaches including genomics to vaccine QA; The Hub in partnership with NIBSC will occupy a unique position as the interface between LMIC manufacturers, regulators, policymakers and cutting-edge academic research. The key outcomes are listed below.

Key outcomes from this workstream
- Develop novel QA assays / Release Criteria / to the various vaccine platforms developed by the Hub and its partners
- Develop QA assays to enable rapid deployment in LMIC setting
- Development of robust QA to benefit modular manufacturing processes across various Hub platforms